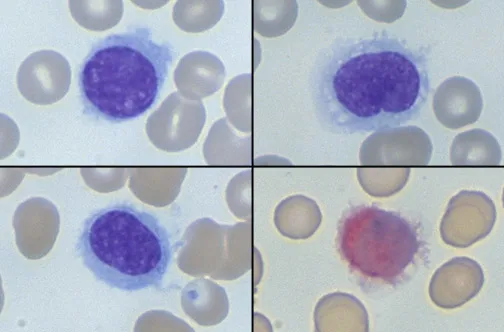
Hairy cell leukemia with TRAP stain

Chronic Leukemias Overview - The Slow Burn
- Insidious onset, primarily affecting older adults.
- Clonal proliferation of more mature-appearing hematopoietic cells.
- Slower progression compared to acute leukemias; often indolent course.
- Frequently discovered incidentally during routine blood work.
- Common features: fatigue, weight loss, splenomegaly, cytopenias (later stages).
- Peripheral blood often shows ↑ specific mature cells.
- Bone marrow is typically hypercellular with lineage-specific proliferation.
⭐ Chronic leukemias are generally insidious in onset and affect older adults, characterized by proliferation of more mature hematopoietic cells.
Chronic Myeloid Leukemia (CML) - Philly's Fatal Fusion
- Myeloproliferative neoplasm (MPN); clonal stem cell disorder.
- 📌 CML = City of Philadelphia, 9:22 PM; t(9;22) (BCR-ABL1 fusion gene).
- Pathophysiology: Constitutively active tyrosine kinase → uncontrolled cell proliferation.
- Key Features:
- Insidious: fatigue, weight loss, splenomegaly.
- Blood: ↑WBC (marked left shift), basophilia, eosinophilia, often thrombocytosis. Low LAP score.
- Phases:
- Chronic: <**10%** blasts.
- Accelerated: **10-19%** blasts, ↑basophils >**20%**, worsening splenomegaly.
- Blast Crisis: ≥**20%** blasts (myeloid/lymphoid).
*
- Diagnosis: Bone marrow: hypercellular. Cytogenetics/FISH/PCR for BCR-ABL1.
⭐ The Philadelphia chromosome t(9;22)(q34;q11.2) resulting in the BCR-ABL1 fusion gene is the pathognomonic hallmark of CML.
- Treatment: Tyrosine Kinase Inhibitors (TKIs) like Imatinib.
Chronic Lymphocytic Leukemia (CLL/SLL) - The Lymphocyte Flood
-
Most common adult leukemia (West); indolent B-cell neoplasm. SLL: tissue form.
-
Patho: Accumulation of clonal, mature but immunoincompetent B-cells.
-
Diagnosis: Absolute lymphocytosis >5000/μL (peripheral blood).
- Smear: Small, mature lymphocytes; smudge cells (Gumprecht shadows).
-
Immunophenotype: CD19+, CD20+(dim), CD5+, CD23+. Surface Ig (dim).
-
Clinical: Often asymptomatic. Fatigue, lymphadenopathy, hepatosplenomegaly. B-symptoms less common.
-
Complications:
- Infections (hypogammaglobulinemia).
- Autoimmune cytopenias (AIHA, ITP).
- Richter's Transformation (to DLBCL, ~2-10%).
-
Staging (Rai Simplified):
⭐ Characteristic immunophenotype for CLL is CD19+, CD20+ (dim), CD5+, and CD23+; smudge cells (crushed lymphocytes) are frequently seen on peripheral blood smears.
Hairy Cell Leukemia (HCL) - Trap 'Em Hairs
- Rare, indolent B-cell neoplasm; M:F 4:1.
- Pathogenesis: BRAF V600E mutation (>90%).
- Clinical:
- Pancytopenia.
- Massive splenomegaly.
- No lymphadenopathy (usually).
- ↑ Susceptibility to atypical mycobacterial infections.
- Morphology:
- Peripheral blood: "Hairy cells" (lymphocytes with fine, circumferential cytoplasmic projections). Monocytopenia is characteristic.
- Bone marrow: "Fried egg" appearance of cells; dry tap on aspiration due to marrow fibrosis (reticulin).
- Key Test:
- 📌 TRAP positive (Tartrate Resistant Acid Phosphatase).
- Immunophenotype: Pan B-cell markers (CD19, CD20, CD22); specific: CD11c, CD25, CD103, Annexin A1.
⭐ Hairy Cell Leukemia is characterized by pancytopenia, massive splenomegaly, 'hairy' B-lymphocytes in peripheral blood/bone marrow, and strong positivity for TRAP stain; BRAF V600E mutation is highly prevalent.
- Rx: Cladribine (2-CdA), Pentostatin. Excellent prognosis with therapy.
High‑Yield Points - ⚡ Biggest Takeaways
- CML: Philadelphia t(9;22), BCR-ABL1; TKIs; low LAP score.
- CLL: Most common adult leukemia; CD5+/CD23+ B-cells, smudge cells; Richter's transformation.
- Hairy Cell Leukemia: BRAF V600E; TRAP positive; "hairy" cells, pancytopenia; cladribine.
- Polycythemia Vera: JAK2 V617F (>90%); ↑RBC mass, low EPO; aquagenic pruritus.
- Essential Thrombocythemia: JAK2/CALR/MPL mutations; marked thrombocytosis; thrombotic/hemorrhagic risk.
- Primary Myelofibrosis: JAK2/CALR/MPL mutations; marrow fibrosis, teardrop RBCs; massive splenomegaly.
Unlock the full lesson and continue reading
Signup to continue reading this lesson and unlimited access questions, flashcards, AI notes, and more